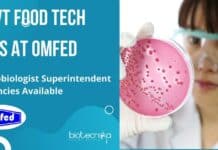
Govt Food Tech Jobs at OMFED – Microbiologist Superintendent Vacancies Available Govt Microbiology Job
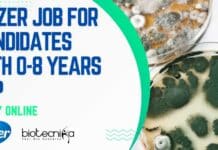
Pfizer Job For Candidates With 0-8 Years Exp – Apply Online Pfizer Microbiology Vacancy 2022

Govt Food Tech Jobs at OMFED – Microbiologist Superintendent Vacancies Available
Govt Microbiology Job at OMFED, Applications Invited
Govt Microbiology Job at OMFED, Applications Invited. Dairy Microbiology/Dairy Technology/ Food Technology/Dairy Chemistry applicants are eligible to apply....
Biotecnika Times Newsletter 22.09.2022 Govt OSSC Jobs, Freshers Clarivate, Pfizers Jobs
Biotecnika Times - Govt OSSC Jobs, Freshers Clarivate, Pfizers Jobs
Govt OSSC Jr. Lab Assistant Recruitment 2022 – Online Applications Invited
Biotechnology Jobs at OSSC –...
Clarivate Job For 0-1 Year Exp Biotech, Life Sciences & Microbiology
Clarivate Content Analyst Job, 0-1 Years Exp Candidates Apply Online
Clarivate Content Analyst Job, 0-1 Years Exp Candidates Apply Online. MSc in Biotechnology, Microbiology, Life...
CSIR-CSMCRI BSc Plant Sciences, MSc Biotech, Biochem Project Job Openings
CSIR-CSMCRI BSc Plant Sciences, MSc Biotech, Biochem Project Job Openings
CSIR-CSMCRI BSc Plant Sciences, MSc Biotech, Biochem Project Job Openings. MSc Project Associate job openings....
GNDU Project Job For MSc Life Sciences, Microbiology – Applications Invited
GNDU Project Job For MSc Life Sciences, Microbiology - Applications Invited
GNDU Project Job For MSc Life Sciences, Microbiology - Applications Invited. Guru Nanak Dev...
CSIR-NEERI SARS-CoV-2 Project Job Openings, Applications Invited
CSIR-NEERI Project Job Opening - Biotech, Microbiology Apply
CSIR-NEERI Project Job Opening - Biotech, Microbiology Apply. MSc project associate job at CSIR-NEERI. CSIR - National...
MNNIT MSc, BTech & MTech Biotech, Biochem, Mol Bio, Life Sciences JRF Job
MNNIT JRF Job For MSc, BTech & MTech Biotech, Biochem, Mol Bio
MNNIT JRF Job For MSc, BTech & MTech Biotech, Biochem, Mol Bio. MSc,...
National Bio Entrepreneurship Competition 2022
National Bio Entrepreneurship Competition 2022
Applications open : 16 September 2022, 12:00 PM
Applications close : 10 October 2022, 05:30 PM
About
Every year C-CAMP organizes National Bio...
Tata Chemicals IP Manager Recruitment For Biotech Candidates, Apply Online
Tata Chemicals IP Manager Recruitment For Biotech Candidates, Apply Online
Tata Chemicals IP Manager Recruitment For Biotech Candidates, Apply Online. MTech Biotech Deputy Manager -...
JIPMER Bioinformatics, Comp Bio & Life Sciences SRF Recruitment 2022
JIPMER Bioinformatics, Comp Bio & Life Sciences SRF Recruitment 2022
JIPMER Bioinformatics, Comp Bio & Life Sciences SRF Recruitment 2022. MSc, MTech & PhD Bioinformatics/...
Govt OSSC Jr. Lab Assistant Recruitment 2022 – Online Applications Invited
Biotechnology Jobs at OSSC - Applications Invited
Biotechnology Jobs at OSSC - Applications Invited. Govt OSSC Jr. Lab Assistant Recruitment 2022. OSSC Recruitment 2022.. Interested...
MSc Biotech & Biochem Candidates Apply Online at CFTRI For Project Job
CFTRI MSc Project Job Opening For Biotech & Biochem - Apply Online
CFTRI MSc Project Job Opening For Biotech & Biochem - Apply Online. CSIR-CFTRI...
Pfizer Job For Candidates With 0-8 Years Exp – Apply Online
Pfizer Microbiology Vacancy 2022 - Candidates With Minimal Exp Can Apply
Pfizer Microbiology Vacancy 2022 - Candidates With Minimal Exp Can Apply. Pfizer is hiring...
Biotecnika Times Newsletter 21.09.2022 NCCS Project Training, CCMB Jobs, CSIR NET Aarambh Batch Launch
Biotecnika Times - NCCS Project Training, CCMB Jobs, CSIR NET Aarambh
NCCS Project Training Programme 2023 In Biological Sciences, 6 Months & 1 Year Sessions...
🔥🚀CSIR NET Aarambh Batch Has Launched – Calling Applications
Biotecnika CSIR NET Classes - Coaching Biotecnika Admission
It's Never too late to start. It's always too late to wait.
Giving you a reason to Kickstart...